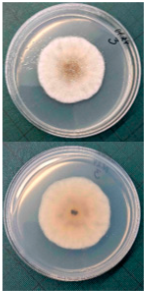
Horticulturae 10 01064 i004 Horticulturae 10 01064 i004

The Impact of Growing Conditions on the Shelf Life and Storage Rot of cv. Rubin Apples
Abstract
1. Introduction
2. Materials and Methods
2.1. Growing Conditions
2.2. Plant Material
2.3. Assessment of Apple Rot during Storage
2.4. Total Phenolic Content Determination
2.5. Determination of Macro- and Microelements
2.6. Statistical Analysis
3. Results
4. Discussion
5. Conclusions
Author Contributions
Funding
Data Availability Statement
Conflicts of Interest
References
- FAOSTAT. Available online: https://www.fao.org/faostat/en/#data/QCL (accessed on 1 October 2023).
- Agarwal, S.; Fulgoni, V.L., III; Welland, D. Intake of 100% fruit juice is associated with improved diet quality of adults: NHANES 2013–2016 analysis. Nutrients 2019, 11, 2513. [Google Scholar] [CrossRef] [PubMed]
- Vallée Marcotte, B.; Verheyde, M.; Pomerleau, S.; Doyen, A.; Couillard, C. Health benefits of apple juice consumption: A review of interventional trials on humans. Nutrients 2022, 14, 821. [Google Scholar] [CrossRef] [PubMed]
- Zhu, D.; Shen, Y.; Wei, L.; Xu, L.; Cao, X.; Liu, H.; Li, J. Effect of particle size on the stability and flavor of cloudy apple juice. Food Chem. 2020, 328, 126967. [Google Scholar] [CrossRef] [PubMed]
- Wang, Y.; Li, W.; Xu, X.; Qiu, C.; Wu, T.; Wei, Q.; Ma, F.; Han, Z. Progress of apple rootstock breeding and its use. Hortic. Plant J. 2019, 5, 183–191. [Google Scholar] [CrossRef]
- Marini, R.P.; Fazio, G. Apple rootstocks: History, physiology, management, and breeding. Hortic. Rev. 2018, 45, 197–312. [Google Scholar]
- Chauhan, A.; Ladon, T.; Verma, P. Strategies for rootstock and varietal improvement in apple: A review. J. Pharmacogn. Phytochem. 2020, 9, 2513–2516. [Google Scholar]
- Fazio, G. Genetics, breeding, and genomics of apple rootstocks. Apple Genome 2021, 105–130. [Google Scholar]
- Musacchi, S.; Serra, S. Apple fruit quality: Overview on pre-harvest factors. Sci. Hortic. 2018, 234, 409–430. [Google Scholar] [CrossRef]
- Mupambi, G.; Anthony, B.M.; Layne, D.R.; Musacchi, S.; Serra, S.; Schmidt, T.; Kalcsits, L.A. The influence of protective netting on tree physiology and fruit quality of apple: A review. Sci. Hortic. 2018, 236, 60–72. [Google Scholar] [CrossRef]
- Laužikė, K.; Uselis, N.; Samuolienė, G. The influence of rootstock and high-density planting on apple cv. Auksis fruit quality. Plants 2021, 10, 1253. [Google Scholar] [CrossRef]
- Kviklys, D.; Viškelis, J.; Liaudanskas, M.; Janulis, V.; Laužikė, K.; Samuolienė, G.; Uselis, N.; Lanauskas, J. Apple fruit growth and quality depend on the position in tree canopy. Plants 2022, 11, 196. [Google Scholar] [CrossRef] [PubMed]
- Mészáros, M.; Hnátková, H.; Čonka, P.; Náměstek, J. Linking mineral nutrition and fruit quality to growth intensity and crop load in apple. Agronomy 2021, 11, 506. [Google Scholar] [CrossRef]
- Kviklys, D.; Samuolienė, G. Relationships among the rootstock, crop load, and sugar hormone signaling of apple tree, and their effects on biennial bearing. Front. Plant Sci. 2020, 11, 1213. [Google Scholar] [CrossRef] [PubMed]
- Atay, E.; Crété, X.; Loubet, D.; Lauri, P.E. Effects of different crop loads on physiological, yield and fruit quality of ‘JoyaTM’apple trees: High crop load decreases maximum daily trunk diameter and does not affect stem water potential. Int. J. Fruit Sci. 2021, 21, 955–969. [Google Scholar] [CrossRef]
- Laužikė, K.; Uselis, N.; Samuolienė, G. The Influence of Agrotechnological Tools on cv. Rubin Apples Quality. Agronomy 2021, 11, 463. [Google Scholar] [CrossRef]
- Kviklys, D.; Viskelis, J.; Lanauskas, J.; Uselis, N.; Liaudanskas, M.; Janulis, V. Effects of growth control on yield and fruit quality of the apple cultivar ‘Rubin’. Agric. Food Sci. 2020, 29, 226–257. [Google Scholar]
- Valiuškaitė, A.; Uselis, N.; Kviklys, D.; Lanauskas, J.; Rasiukevičiūtė, N. The effect of sustainable plant protection and apple tree management on fruit quality and yield. Zemdirb. Agric. 2017, 104, 353–358. [Google Scholar] [CrossRef]
- Xanthopoulos, G.T.; Templalexis, C.G.; Aleiferis, N.P.; Lentzou, D.I. The contribution of transpiration and respiration in water loss of perishable agricultural products: The case of pears. Biosyst. Eng. 2017, 158, 76–85. [Google Scholar] [CrossRef]
- Tu, K.; Nicolaï, B.; De Baerdemaeker, J. Effects of relative humidity on apple quality under simulated shelf temperature storage. Sci. Hortic. 2000, 85, 217–229. [Google Scholar] [CrossRef]
- Maguire, K.M.; Banks, N.H.; Opara, L.U. Factors affecting weight loss of apples. Hortic. Rev. 2010, 25, 197–234. [Google Scholar]
- Lufu, R.; Ambaw, A.; Opara, U.L. Water loss of fresh fruit: Influencing pre-harvest, harvest and postharvest factors. Sci. Hortic. 2020, 272, 109519. [Google Scholar] [CrossRef]
- Ndubizu, T. Relations of phenolic inhibitors to resistance of immature apple fruits to rot. J. Hortic. Sci. 1976, 51, 311–319. [Google Scholar] [CrossRef]
- Calì, M.; Amaral Carneiro, G.; Cappelletti, E.; Bugiani, R.; Baschieri, T.; Baroncelli, R.; Prodi, A. First report of Colletotrichum grossum causing apple bitter rot worldwide (Italy). Plant Dis. 2023, 108, 218. [Google Scholar] [CrossRef]
- Khodadadi, F.; Giroux, E.; Bilodeau, G.J.; Jurick, W.M.; Aćimović, S.G. Genomic Resources of Four Colletotrichum Species (C. fioriniae, C. chrysophilum, C. noveboracense, and C. nupharicola) Threatening Commercial Apple Production in the Eastern United States. Mol. Plant Microbe Interact. 2023, 36, 529–532. [Google Scholar] [CrossRef] [PubMed]
- Kumari, N.; Sharma, J.N.; Singh, D.; Thakur, A.K. Major storage rots of apple: Occurrences and distribution. Int. J. Econ. Plants 2018, 5, 046–052. [Google Scholar] [CrossRef]
- Rogério, F.; Boufleur, T.R.; Ciampi-Guillardi, M.; Sukno, S.A.; Thon, M.R.; Massola Junior, N.S.; Baroncelli, R. Genome sequence resources of Colletotrichum truncatum, C. plurivorum, C. musicola, and C. sojae: Four species pathogenic to soybean (Glycine max). Phytopathology 2020, 110, 1497–1499. [Google Scholar] [CrossRef]
- Kovacevik, B.; Mitrev, S. Phenotypic and pathogenic characterization of Colletotrichum spp. associated with bitter rot on apple fruits in post-harvest storage. In Proceedings of the 2nd International Meeting Agriscience & Practice, Stip, Republic of Macedonia, 12 April 2019. [Google Scholar]
- Argenta, L.C.; de Freitas, S.T.; Mattheis, J.P.; Vieira, M.J.; Ogoshi, C. Characterization and quantification of postharvest losses of apple fruit stored under commercial conditions. HortScience 2021, 56, 608–616. [Google Scholar] [CrossRef]
- Youssef, K.; Roberto, S.R. Premature Apple Fruit Drop: Associated Fungal Species and Attempted Management Solutions. Horticulturae 2020, 6(2), 31. [Google Scholar] [CrossRef]
- Ainsworth, E.A.; Gillespie, K.M. Estimation of Total Phenolic Content and Other Oxidation Substrates in Plant Tissues Using Folin–Ciocalteu Reagent. Nature Protoc. 2007, 2, 875–877. [Google Scholar] [CrossRef]
- Konopacka, D.; Rutkowski, K.; Płocharski, W. Changes of acceptability of ‘Jonagold’ and ‘Gala’ apples during storage in normal atmosphere. J. Fruit Ornam. Plant Res. 2007, 66, 177–186. [Google Scholar] [CrossRef]
- Díaz-Pérez, J.C.; Muy-Rangel, M.D.; Mascorro, A.G. Fruit size and stage of ripeness affect postharvest water loss in bell pepper fruit (Capsicum annuum L.). HortScience 2006, 41, 68–73. [Google Scholar] [CrossRef]
- Johnston, J.W.; Hewett, E.W.; Hertog, M.L.; Harker, F.R. Harvest date and fruit size affect postharvest softening of apple fruit. J. Hortic. Sci. Biotechnol. 2002, 77, 355–360. [Google Scholar] [CrossRef]
- Baïram, E.; Lemorvan, C.; Delaire, M.; Buck-Sorlin, G. Fruit and leaf response to different source–sink ratios in apple, at the scale of the fruit-bearing branch. Front. Plant Sci. 2019, 10, 1039. [Google Scholar] [CrossRef] [PubMed]
- Faghih, S.; Zamani, Z.; Fatahi, R.; Omidi, M. Influence of kaolin application on most important fruit and leaf characteristics of two apple cultivars under sustained deficit irrigation. Biol. Res. 2021, 54. [Google Scholar] [CrossRef] [PubMed]
- Patriarca, A. Fungi and mycotoxin problems in the apple industry. Curr. Opin. Food Sci. 2019, 29, 42–47. [Google Scholar] [CrossRef]
- Grabowski, M.F. Incidence of postharvest fungal diseases of apples in integrated fruit production. Acta Sci. Pol. Hortorum Cultus 2021, 20, 123–129. [Google Scholar] [CrossRef]
- Michalecka, M.; Bryk, H.; Poniatowska, A.; Puławska, J. Identification of Neofabraea species causing bull’s eye rot of apple in Poland and their direct detection in apple fruit using multiplex PCR. Plant Pathol. 2016, 65, 643–654. [Google Scholar] [CrossRef]
- Grantina-Ievina, L. Fungi causing storage rot of apple fruit in integrated pest management system and their sensitivity to fungicides. Rural. Sustain. Res. 2015, 34, 2–11. [Google Scholar] [CrossRef]
- Sun, Y.; Lin, M.; Chen, Y.; Chen, X.; Cai, Y.; Luo, H.; Zhou, T. A study of the major pathogens causing fruit rots of apple in shelf life in Hangzhou, Zhejiang Province, China. Am. J. Plant Sci. 2019, 10, 2070. [Google Scholar] [CrossRef][Green Version]
- Schloffer, K.; Trapman, M. Hot water shower against Gloeosporium fruit rot in organic apple production-how to introduce a new system from research to practice. In Proceedings of the IOBC/WPRS Working Group “Integrated Plant Protection in Fruit Crops, Subgroup Pome Fruit Diseases”, Stellenbosch, South Africa, 24–28 November 2014; Volume 110, pp. 191–198. [Google Scholar]
- Prunier, C.; Klein, N.; Neuwald, D.A. Hot water treatment-using the apples own defence potential. In Proceedings of the 18th International Conference on Organic Fruit-Growing, Hohenheim, Germany, 19–21 February 2018; pp. 121–123. [Google Scholar]
- Gabioud Rebeaud, S.; Cotter, P.Y.; Christen, D. Ozone as an alternative method to control postharvest diseases on apples. In Proceedings of the V International Symposium on Postharvest Pathology: From Consumer to Laboratory-Sustainable Approaches to Managing Postharvest Pathogens, Liège, Belgium, 19–24 May 2019; Volume 1325, pp. 259–264. [Google Scholar]
- Ivan, E.S.; Ciceoi, R.; Jerca, I.O.; Nițu, O.A.; Stan, A. Postharvest pathology of organic apples from Romania. Preliminary study. Sci. Papers. Ser. B Hortic. 2019, Volume 63, 81–84. [Google Scholar]
- Ntasiou, P.; Myresiotis, C.; Konstantinou, S.; Papadopoulou-Mourkidou, E.; Karaoglanidis, G.S. Identification, characterization and mycotoxigenic ability of Alternaria spp. causing core rot of apple fruit in Greece. Int. J. Food Microbiol. 2015, 197, 22–29. [Google Scholar] [CrossRef] [PubMed]
- Spadaro, D.; Torres, R.; Errampalli, D.; Everett, K.; Ramos, L.; Mari, M. Pome Fruits Postharvest Pathology of Fresh Horticultural Produce; CRC Press: Boca Raton, FL, USA, 2019; pp. 55–110. [Google Scholar]
- Errampalli, D. Penicillium expansum (blue mold). In Postharvest Decay; Acadamic Press: Cambridge, MA, USA, 2014; pp. 189–231. [Google Scholar]
- Khan, I.H.; Javaid, A. Molecular characterization of Penicillium expansum associated with blue mold disease of apple in Pakistan. Pak. J. Bot. 2021, 53, 2299–2303. [Google Scholar] [CrossRef] [PubMed]
- McCulloch, M.J.; Gauthier, N.W.; Vaillancourt, L.J. First report of bitter rot of apple caused by a Colletotrichum sp. in the C. kahawae clade in Kentucky. Plant Dis. 2020, 104, 289. [Google Scholar] [CrossRef]
- Leonberger, K.; McCulloch, M.; Gauthier, N.W. Bitter Rot of Apple; Plant Pathology Fact Sheet; University of Kentucky, College of Agriculture, Food and Environment: Lexington, KY, USA, 2019. [Google Scholar]
- Lee, S.Y.; Ten, L.N.; Ryu, J.J.; Kang, I.K.; Jung, H.Y. Colletotrichum aenigma associated with apple bitter rot on newly bred cv. RubyS Apple. Res. Plant Dis. 2021, 27, 70–75. [Google Scholar] [CrossRef]
- Feng, S.; Yi, J.; Li, X.; Wu, X.; Zhao, Y.; Ma, Y.; Bi, J. Systematic review of phenolic compounds in apple fruits: Compositions, distribution, absorption, metabolism, and processing stability. J. Agric. Food Chem. 2021, 69, 7–27. [Google Scholar] [CrossRef] [PubMed]
- Vondráková, Z.; Trávníčková, A.; Malbeck, J.; Haisel, D.; Černý, R.; Cvikrová, M. The effect of storage conditions on the carotenoid and phenolic acid contents of selected apple cultivars. Eur. Food Res. Technol. 2020, 246, 1783–1794. [Google Scholar] [CrossRef]
- Bílková, A.; Baďurová, K.; Svobodová, P.; Vávra, R.; Jakubec, P.; Chocholouš, P.; Švec, F.; Sklenářová, H. Content of major phenolic compounds in apples: Benefits of ultra-low oxygen conditions in long-term storage. J. Food Compos. Anal. 2020, 92, 103587. [Google Scholar] [CrossRef]
- Łysiak, G.P.; Michalska-Ciechanowska, A.; Wojdyło, A. Postharvest changes in phenolic compounds and antioxidant capacity of apples cv. Jonagold growing in different locations in Europe. Food Chem. 2020, 310, 125912. [Google Scholar] [CrossRef]
- Lv, Y.; Tahir, I.I.; Olsson, M.E. Effect of ozone application on bioactive compounds of apple fruit during short-term cold storage. Sci. Hortic. 2019, 253, 49–60. [Google Scholar] [CrossRef]
- Rahmati-Joneidabad, M. Identification of chemical compounds of Ocimum basilicum essential oil and its effect on inhibiting the growth of fungi causing postharvest rots in apple. Res. Plant Metab. 2022, 1, 11–23. [Google Scholar]
- El Khetabi, A.; Ezrari, S.; El Ghadraoui, L.; Tahiri, A.; Ait Haddou, L.; Belabess, Z.; Merah, O.; Lahlali, R. In vitro and in vivo antifungal activities of nine commercial essential oils against brown rot in apples. Horticulturae 2021, 7, 545. [Google Scholar] [CrossRef]
- Schiavon, G.; Garello, M.; Prencipe, S.; Meloni, G.R.; Buonsenso, F.; Spadaro, D. Essential oils reduce grey mould rot of apples and modify the fruit microbiome during postharvest storage. J. Fungi 2022, 9, 22. [Google Scholar] [CrossRef] [PubMed]
- Tokaseva, D.S.; Iksat, N.N.; Omarov, R.T. Magnesium and manganese biological role in crops diseases. Bulletin of the Eurasian National University named after LN Gumilyov. Ser. Biol. Sci. 2020, 1, 31–36. [Google Scholar]
- Chatzidimopoulos, M.; Lioliopoulou, F.; Sotiropoulos, T.; Vellios, E. Efficient control of apple scab with targeted spray applications. Agronomy 2020, 10, 217. [Google Scholar] [CrossRef]
- Rademacher, W.; Kober, R. Efficient use of prohexadione-Ca in pome fruits. Eur. J. Hortic. Sci. 2003, 68, 101–107. [Google Scholar]
- Diwan, G.; Sahu, M.K.; Tiwari, S.; Ahirwar, K.; Haldar, A.; Rangare, N.R.; Banjare, K.; Kumar, S.; Ahirwar, M.; Samaiya, R.K. Effect of New Plant Growth Regulator Prohexadione-Ca on Horticultural Crops. Agric. Mech. Asia 2022, 53, 9671–9681. [Google Scholar]
- Srivastava, J.N.; Singh, A.K.; Sharma, R.K. Diseases of apples and their management. In Diseases of Fruits and Vegetable Crops; Apple Academic Press: Palm Bay, FL, USA, 2020; pp. 19–39. [Google Scholar]
- Behlau, F.; Lanza, F.E.; da Silva Scapin, M.; Scandelai, L.H.M.; Silva Junior, G.J. Spray volume and rate based on the tree row volume for a sustainable use of copper in the control of citrus canker. Plant Dis. 2021, 105, 183–192. [Google Scholar] [CrossRef]
- Garton, W.J.; Mazzola, M.; Alexander, T.R.; Miles, C.A. Efficacy of fungicide treatments for control of anthracnose canker in young cider apple trees in Western Washington. HortTechnology 2019, 29, 35–40. [Google Scholar] [CrossRef]

| Storage Duration | Apple Rot Incidence % | DW/FW% | TPC mg g−1 DW | Water Loss% |
|---|---|---|---|---|
| 0 days | 0.000 b | 11.739 b | 3.463 b | 0.000 b |
| 180 days | 21.667 a | 13.480 a | 6.919 a | 1.973 a |
| Apple Rot Incidence | Yield | Yield | Average Fruit Size | Coloring | |
|---|---|---|---|---|---|
| % | t ha−1 | kg tree−1 | g | % | |
| Manual pruning—Super spindle (as the control) | 5.0 ± 0.00 d | 25.4 ± 3.00 bc | 11.1 ± 1.31 bc | 222.3 ± 2.12 a | 57.8 ± 1.01 a |
| Manual pruning—Super spindle with long branches | 10.0 ± 8.66 d | 24.3 ± 2.87 c | 10.6 ± 1.25 c | 212.8 ± 9.95 ab | 51.8 ± 0.85 bc |
| Mechanical pruning with manual pruning a year ago (every two years) | 20.0 ± 0.00 c | 32.1 ± 3.78 abc | 14.0 ± 1.65 abc | 188.4 ± 1.78 e | 49.5 ± 1.63 c |
| Mechanical pruning with manual pruning in the year of harvest | 5.0 ± 0.00 d | 42.2 ± 4.97 a | 18.5 ± 2.18 a | 192.6 ± 2.71 de | 41.3 ± 1.21 e |
| Mechanical pruning + manual pruning + trunk cutting by chainsaw | 40.0 ± 0.00 a | 34.8 ± 4.10 ab | 15.2 ± 1.79 ab | 189.2 ± 1.36 e | 53.6 ± 1.01 b |
| Mechanical pruning + manual pruning + Ca-prohexadione 0.9 kg ha−1 3 times | 33.3 ± 11.55 ab | 27.6 ± 3.26 bc | 12.1 ± 1.42 bc | 200.4 ± 0.96 cd | 51.3 ± 1.21 bc |
| Mechanical pruning + summer pruning | 33.3 ± 11.55 ab | 25.7 ± 3.03 bc | 11.3 ± 1.33 bc | 194.3 ± 2.15 de | 45.5 ± 1.00 d |
| Mechanical pruning by one side, changing every pruning | 26.7 ± 11.55 b | 28.2 ± 3.33 bc | 12.4 ± 1.46 bc | 206.4 ± 1.70 bc | 50.3 ± 1.03 bc |
| Rot on apple | ![]() | ![]() | ![]() |
| Fungal colonies isolated from rot | ![]() | ![]() | ![]() |
| Example of fungal spores | ![]() | ![]() | ![]() |
| Rot name | Alternaria fruit spot. (Alternaria spp.), Gloeosporium rot (Neofabraea spp.), blue rot (Penicillium spp.) | Gloeosporium rot (Neofabraea spp.), blue rot (Penicillium spp.) | Bitter rot (Colletotrichum spp.) |
| DW/FW | DW/FW Storage | Water Loss during Storage | Total Phenol Content | Total Phenol Content, Storage | |
|---|---|---|---|---|---|
| % | % | % | mg g−1 DW | mg g−1 DW | |
| Manual pruning—Super spindle (as control) | 12.1 ± 0.33 ab | 14.1 ± 0.34 a | 2.28 ± 0.13 a | 3.0 ± 0.21 a | 3.0 ± 0.61 b |
| Manual pruning—Super spindle with long branch | 12.5 ± 0.33 a | 13.9 ± 0.41 a | 1.61 ± 0.22 cd | 3.2 ± 0.49 a | 8.5 ± 1.14 a |
| Mechanical pruning with manual pruning a year ago (every two years) | 11.5 ± 0.28 ab | 13.1 ± 0.66 ab | 1.78 ± 1.03 bc | 2.9 ± 0.17 a | 8.4 ± 1.84 a |
| Mechanical pruning with manual pruning in the year of harvest | 11.6 ± 0.51 ab | 13.0 ± 0.10 b | 1.58 ± 0.60 d | 3.8 ± 0.63 a | 7.6 ± 0.56 a |
| Mechanical pruning + manual pruning + trunk cutting by chainsaw | 12.0 ± 0.60 ab | 14.1 ± 0.3 a | 2.04 ± 0.89 ab | 3.3 ± 0.30 a | 7.8 ± 0.40 a |
| Mechanical pruning + manual pruning + Ca-prohexadione 0.9 kg ha−1 3 times | 11.3 ± 0.23 b | 13.2 ± 0.50 ab | 2.13 ± 0.79 ab | 4.2 ± 0.93 a | 7.0 ± 0.17 a |
| Mechanical pruning + summer pruning | 11.1 ± 0.36 b | 12.8 ± 0.58 b | 1.99 ± 0.36 b | 4.0 ± 1.12 a | 7.6 ± 0.89 a |
| Mechanical pruning by one side, changing every pruning | 12.0 ± 0.33 ab | 13.8 ± 0.61 a | 1.98 ± 0.38 b | 3.3 ± 0.45 a | 7.6 ± 0.22 a |
| Mg | K | Ca | Cu | |
|---|---|---|---|---|
| mg g−1 DW | mg g−1 DW | mg g−1 DW | µg g−1 DW | |
| Manual pruning—Super spindle (as control) | 0.065 ± 0.001 ab | 0.76 ± 0.012 b | 0.123 ± 0.007 bc | 0.44 ± 0.017 c |
| Manual pruning—Super spindle with long branch | 0.062 ± 0.001 b | 0.78 ± 0.023 b | 0.117 ± 0.005 c | 0.41 ± 0.023 c |
| Mechanical pruning with manual pruning a year ago (every two years) | 0.066 ± 0.002 ab | 0.83 ± 0.018 ab | 0.121 ± 0.008 bc | 0.51 ± 0.062 bc |
| Mechanical pruning with manual pruning in the year of harvest | 0.063 ± 0.001 b | 0.81 ± 0.018 ab | 0.132 ± 0.007 abc | 0.58 ± 0.047 ab |
| Mechanical pruning + manual pruning +t runk cut by chain saw | 0.065 ± 0.004 ab | 0.80 ± 0.043 ab | 0.138 ± 0.011 ab | 0.62 ± 0.021 ab |
| Mechanical pruning + manual pruning + Ca-prohexadione 0.9 kg ha−1 3 times | 0.068 ± 0.005 ab | 0.87 ± 0.080 ab | 0.123 ± 0.006 bc | 0.62 ± 0.047 a |
| Mechanical pruning + summer pruning | 0.067 ± 0.006 ab | 0.82 ± 0.065 ab | 0.132 ± 0.002 abc | 0.70 ± 0.079 a |
| Mechanical pruning by one side, changing every pruning | 0.073 ± 0.003 a | 0.91 ± 0.025 a | 0.143 ± 0.002 a | 0.70 ± 0.018 a |
| Variables | DW/FW | TPC | Mg | K | Ca | Cu | Yield | Apple Rot Incidence | DW/FW Storage | TPC Storage | Water Loss | Average Fruit Size | Coloring |
|---|---|---|---|---|---|---|---|---|---|---|---|---|---|
| DW/FW | 1 | −0.416 | −0.265 | −0.242 | −0.158 | −0.492 | −0.065 | −0.269 | 0.612 | 0.032 | −0.292 | 0.533 | 0.434 |
| TPC | 1 | 0.328 | 0.430 | 0.226 | 0.537 | −0.017 | 0.242 | −0.140 | 0.064 | 0.259 | −0.127 | −0.365 | |
| Mg | 1 | 0.868 | 0.467 | 0.605 | −0.143 | 0.315 | −0.042 | −0.163 | 0.223 | −0.024 | 0.014 | ||
| K | 1 | 0.380 | 0.632 | 0.072 | 0.272 | −0.180 | 0.179 | 0.032 | −0.190 | −0.222 | |||
| Ca | 1 | 0.618 | 0.255 | 0.343 | 0.145 | −0.159 | 0.339 | −0.276 | −0.257 | ||||
| Cu | 1 | 0.092 | 0.683 | −0.256 | 0.153 | 0.198 | −0.451 | −0.356 | |||||
| Yield | 1 | −0.089 | −0.317 | 0.162 | −0.317 | −0.514 | −0.489 | ||||||
| Apple rot incidence | 1 | −0.092 | 0.060 | 0.167 | −0.426 | 0.048 | |||||||
| DW/FW storage | 1 | −0.275 | 0.578 | 0.471 | 0.628 | ||||||||
| TPC storage | 1 | −0.366 | −0.334 | −0.479 | |||||||||
| Water loss | 1 | 0.021 | 0.313 | ||||||||||
| Average fruit size | 1 | 0.564 | |||||||||||
| Coloring | 1 |
Disclaimer/Publisher’s Note: The statements, opinions and data contained in all publications are solely those of the individual author(s) and contributor(s) and not of MDPI and/or the editor(s). MDPI and/or the editor(s) disclaim responsibility for any injury to people or property resulting from any ideas, methods, instructions or products referred to in the content. |
© 2024 by the authors. Licensee MDPI, Basel, Switzerland. This article is an open access article distributed under the terms and conditions of the Creative Commons Attribution (CC BY) license (https://creativecommons.org/licenses/by/4.0/).
Share and Cite
Laužikė, K.; Gudžinskaitė, I.; Dėnė, L.; Samuolienė, G. The Impact of Growing Conditions on the Shelf Life and Storage Rot of cv. Rubin Apples. Horticulturae 2024, 10, 1064. https://doi.org/10.3390/horticulturae10101064
Laužikė K, Gudžinskaitė I, Dėnė L, Samuolienė G. The Impact of Growing Conditions on the Shelf Life and Storage Rot of cv. Rubin Apples. Horticulturae. 2024; 10(10):1064. https://doi.org/10.3390/horticulturae10101064
Chicago/Turabian StyleLaužikė, Kristina, Ieva Gudžinskaitė, Lina Dėnė, and Giedrė Samuolienė. 2024. "The Impact of Growing Conditions on the Shelf Life and Storage Rot of cv. Rubin Apples" Horticulturae 10, no. 10: 1064. https://doi.org/10.3390/horticulturae10101064
APA StyleLaužikė, K., Gudžinskaitė, I., Dėnė, L., & Samuolienė, G. (2024). The Impact of Growing Conditions on the Shelf Life and Storage Rot of cv. Rubin Apples. Horticulturae, 10(10), 1064. https://doi.org/10.3390/horticulturae10101064